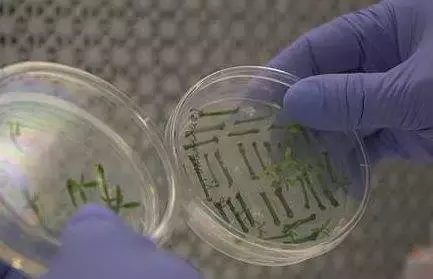
11月食品安全最热新闻月度排行榜丨食安舆情

食品安全头条专注食品安全重要舆情,每月分享食品行业热点舆情事件,将精华新闻一网打尽。
食品行业月度舆情排行榜以每月发生的热点舆情事件为考察样本,主要评估舆情事件在媒体报道、微传播(微博微信)和网络问政三个方面的传播力和影响力,采用定量研究与定性分析相结合的方法,最终量化统计出月度食品行业舆情排行榜。
本月经过热点追踪、及时反馈敏感信息,准确把握舆情势,最终统计10月食品安全舆情榜如下:

TOP1O

近日,北京市消协对23个茶叶样品进行抽样调查。结果显示,有13个样品存在感官品质不符合其明示质量等级。3个样品并非来自西湖,其产地标注为福建,但福建不产龙井茶。有的龙井茶甚至农药残留超标。可以说,龙井茶的整体质量水平不容乐观。
比较试验中,有4个假冒西湖产区的龙井茶,分别是:杭州御峰茶叶有限公司生产的中狮西湖龙井茶;昆明七彩云南庆沣祥茶业股份有限公司生产的七彩云南牌梅家坞龙井;杭州西湖名茶有限公司茶厂生产的乾龙牌西湖龙井;杭州之江茶叶有限公司生产的狮峰牌西湖龙井。
市消协方面分析,由于在超市和网上商城销售的茶叶以礼盒形式居多,消费者在购买茶叶时大多数情况下是无法看见茶叶包装内的实物,部分茶叶生产商(或销售商)也正是利用了这一点,通过虚标质量等级和虚标产地等方式来欺骗消费者。

TOP9
哈尔滨呼兰区发生疑似酒精中毒事件 1人已死亡

11月27日,哈尔滨呼兰区市场监管部门接到举报,同时区公安分局110指挥中心接到报案,2018年11月25日呼兰区一酒店就餐人员饮酒后发生疑似中毒现象。11月26日、27日,有5人相继到医院就医,其中有1人27日死亡。
目前已对酒厂部分商品查封,已经取样、送检。区卫计部门积极协调相关医院对伤者进行全力救治;相关部门对死者家属进行抚慰并做好善后处理工作。经初步检测,该事件疑似为酒精中毒引发,公安部门已经开展深入调查。

TOP8

10月29日晚,六合区市场监督管理局接到举报称,南京大生冷链股份有限公司将储存的腐烂冷冻肉制品装车出库。
据搬运工人称“这些肉进来的时候臭得不得了,走私货,这个冷链是专门处理食品的,弄过来以后会有专业的人处理,用药水泡之类的再发出去。”这些肉大概是近 20 天之内运过来的,运来的时候就是腐臭的。
至于肉从哪里运来,他们并不知道。这些保存在B603号冷库的鸡爪、鹅爪、猪肚等肉品来自巴西、丹麦、波兰等国家,均已严重腐烂变质。执法人员立即赶到现场,当场对约100吨问题冷冻肉制品进行查封扣押。

TOP7

11月8日,环翠区温泉学校组织“家长开放日”活动,在参观学校食堂过程中,有家长发现餐柜中摆放一盆黑油,盆底还有黑色沉淀物。校方称,学校食堂承包给山东兴顺餐饮管理有限公司。威海市环翠区食品药品监督管理局11月9日回应,当地药监部门已介入调查。
威海市环翠区政府新闻办官微通报称,经查,排除上述餐饮企业通过非法渠道购进油品的问题,但存在重复用油行为。家长反映的深色油渣物,为该校食堂炸过肉片后的沉淀油渣,执法人员前往取证时,已被涉事企业员工倒掉。通报指出,调查取证期间,区教育局约谈该餐饮公司主要负责人,决定停止该企业在温泉学校的服务。新的餐饮企业11月12日入驻温泉学校,以解决当前学生就餐问题。
11月13日,环翠区人民政府新闻办公室官方微博发布处罚决定。经查,认定温泉学校食堂存在使用色泽异常、有残渣等沉淀物的食用油加工饭菜的违法行为,对温泉学校作出罚没款103016.5元的处罚决定。依据合同约定及相关法律规定,该罚没款由山东兴顺餐饮管理有限公司承担。

TOP6

近日,首届中国国际进口博览会“一带一路”生态农业与食品安全论坛上,市场监管总局局长张茅表示,过去只惩罚企业,赔偿消费者,而且处罚数额有限,不利于震慑违法违规企业。今后,在涉及人民群众健康安全的领域,都要加大对消费者的赔偿力度,保障消费者的合法权益。
要借鉴处理“长春、长生”疫苗事件的教训,在一些制度机制上进行改革创新,包括建立巨额的赔偿制度。

TOP5
西凤年份酒塑化剂超标

11月7日,上海国际酒业交易中心股份有限公司在其官网上披露的一份检测报告显示:西凤•国典凤香50年年份酒2012[珍藏版]的两项塑化相关化学添加剂的含量,均接近限定标准的三倍。对此,西凤股份发布公告称,该批次年份酒是在2012年5月定制生产。在2013年的白酒检测中,不含DBP指标检验项目,因此完全符合彼时(GB/T19508-2007)的安全标准。
但是目前仍有部分该批次产品在市场流通,出于负责态度,在报请陕西省食品药品监督管理局批示后,启动召回。西凤酒具体召回方案为,经销商或消费者持有召回产品,以55度西凤酒1915年产品置换,或按照出厂价进行回购。
11月19日晚间,证监会官网发布的第十七届发审委2018年第175次工作会议公告的补充公告显示,鉴于西凤酒已向证监会申请撤回申报材料,证监会决定取消第十七届发审委2018年第175次发审委会议对该公司发行申报文件的审核,这也意味着西凤酒的上市计划未能如愿。

TOP4

11月1日,茅台集团方面传来重大人事消息,曾任贵州省安顺市委常委副市长郭伟谊出任中国贵州茅台酒厂(集团)有限责任公司总经理,兼任贵州茅台酒股份有限公司董事长与贵州茅台酒销售公司董事长,原先茅台集团总经理与贵州茅台董事长均为李保芳。
10月31日下午,茅台集团召开领导干部大会。贵州省国资委党委副书记陈亮贵在会上宣布,李静仁任茅台集团副总经理、总会计师,原总会计师杨建军卸任。茅台上市公司副总经理、茅台销售公司董事长王崇琳调任贵州省交通建设集团副总、党委委员。

TOP3

近日,2018年未来科学大奖颁奖典礼在北京举行。李家洋、袁隆平、张启发、马大为、冯小明、周其林、林本坚7位科学家获颁2018年未来科学大奖。
其中,“生命科学奖”授予李家洋、袁隆平、张启发3位科学家,表彰他们在推动水稻产量可持续增长的“命题”下获得了重大成就,他们的原创性工作对中国在基础科学领域以及国计民生的巨大影响博得国际科学界的公认。
中国工程院院士袁隆平团队选育的超级杂交稻品种湘两优900(超优千号),在河北省硅谷农科院超级杂交稻示范基地,通过了该省科技厅组织的测产验收。平均亩产1149.02公斤,即每公顷17.2吨。创造了世界水稻单产的最新、最高纪录。
国家水稻数据中心数据显示该品种整个生育期表现良好,10月5日初步实收测产时,亩穗数19.5万,成穗率78.6%,每穗粒总数304粒,结实率90%,千粒重25.5克,穗粒数273.6粒,预测亩产理论产量在1357.4公斤。
截至11月22日0点,微博上,“#袁隆平获未来科学大奖”话题,已经有8.4万条讨论,2.2亿阅读,一度成为热搜榜第一名。

TOP2
长春地区狂犬疫苗再曝问题,两家企业十万瓶被拒签发

11月21日,中国食品药品检定研究院发布公示,不予签发两家企业生产的人用狂犬病疫苗,合计约10万瓶。不予签发意味着该产品无法获得上市许可。两家被拒企业均为长春地区的生物制药企业。
巧合的是,两家被拒企业均为长春地区的生物制药企业。这引起了舆论大众的注意,毕竟距离上次长生生物科技假疫苗事件还没多久,所有人心中的阴影还没消退。
公开信息显示,两家被拒企业中的吉林迈丰生物药业有限公司位于吉林省长春市,生产地点在高新技术开发区。另一家被拒企业是长春卓谊生物股份有限公司,其位于长春市双阳经济开发区。是浙江赛尔康宁生物科技有限公司投资的吉林省重点扶持疫苗生产企业。

TOP1
第一批DNA“编辑”食品即将上市
近日,美国农业部做出一项重要决定,将批准使用CRISPR基因编辑技术生产的作物进入市场。
CRISPR作物是利用CRISPR基因编辑技术精确调控作物DNA后生产出的食品,它具有更长的保质期、更好的风味、或者能够在严重干旱环境中生长的诸多优良基因。一些外媒评价称,以前在对使用任何生物技术(如转基因生物GMO)的食品上实施了严厉而漫长的生产监管限制,而此次美国的决定在一定程度上避开或打破了这一规定。
版权声明:我们致力于保护作者版权,注重分享,被刊用文章【威海学校黑油(11月食品安全最热新闻月度排行榜丨食安舆情)】因无法核实真实出处,未能及时与作者取得联系,或有版权异议的,请联系管理员,我们会立即处理! 部分文章是来自自研大数据AI进行生成,内容摘自(百度百科,百度知道,头条百科,中国民法典,刑法,牛津词典,新华词典,汉语词典,国家院校,科普平台)等数据,内容仅供学习参考,不准确地方联系删除处理!;
工作时间:8:00-18:00
客服电话
电子邮件
beimuxi@protonmail.com
扫码二维码
获取最新动态
